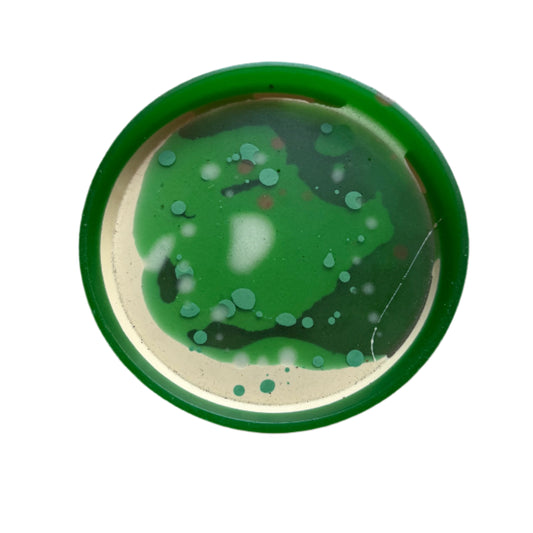
Mega Coaster

-

Sold outMega Coaster
Regular price $15.00 USDRegular priceUnit price perSale price $15.00 USDSold out -
Sold outMega Resin Coaster
Regular price $18.00 USDRegular priceUnit price perSale price $18.00 USDSold out -
Melville Ceramic Striped Mug
Regular price $50.00 USDRegular priceUnit price perSale price $50.00 USD -
Melville Ceramic Striped Vase
Regular price $80.00 USDRegular priceUnit price perSale price $80.00 USD -
Sold outMen To Avoid in Art and Life
Regular price $14.95 USDRegular priceUnit price perSale price $14.95 USDSold out -
Mescalito Travel Fragrance
Regular price $21.00 USDRegular priceUnit price perSale price $21.00 USD -
Metal Napkin Holder
Regular price $20.00 USDRegular priceUnit price perSale price $20.00 USD -
Mexican Napkin
Regular price $12.00 USDRegular priceUnit price perSale price $12.00 USD -
Mexican Saints Wallet
Regular price $4.00 USDRegular priceUnit price perSale price $4.00 USD -

Sold outMexico Cookbook
Regular price $54.95 USDRegular priceUnit price perSale price $54.95 USDSold out -
Mexico Day of the Dead
Regular price $40.00 USDRegular priceUnit price perSale price $40.00 USD -
Mighty Mega Markers
Regular price $11.36 USDRegular priceUnit price perSale price $11.36 USD -
Milagro Decoration Kit
Regular price $30.00 USDRegular priceUnit price perSale price $30.00 USD -
Millicent Rialto Coupe
Regular price $40.00 USDRegular priceUnit price perSale price $40.00 USD -
Mineral Melt
Regular price $29.95 USDRegular priceUnit price perSale price $29.95 USD